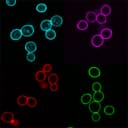

Concanavalin A, CF®594 Conjugate
CAT:
37-29017
Size:
5x 1 mg
Price:
Ask
- Availability: 24/48H Stock Items & 2 to 6 Weeks non Stock Items.
- Dry Ice Shipment: No

Concanavalin A, CF®594 Conjugate
Description:
This product is fluorescently-labeled concanavalin A (Con A). Con A is a widely used lectin that selectively binds to a-mannopyranosyl and a-glucopyranosy residues, found in the cell wall of yeast and fungi, and the cell membrane of mammalian cells. CF® dyes are Biotium's line of next-generation fluorescent dyes with advantages in brightness, photostability, and conjugate specificity compared to other fluorescent dyes. Deep-red fluorescent CF®594 dye has excitation/emission at 593/614 nm.UNSPSC:
41116113UNSPSC Description:
Cytology reagents or solutions or stainsSource:
Plant; Lectin from Jack bean (Canavalia ensiformis)Storage Conditions:
-35°C; Protect from lightShelf Life:
12 months
DATASHEET Document
View DocumentMSDS Document
View Document